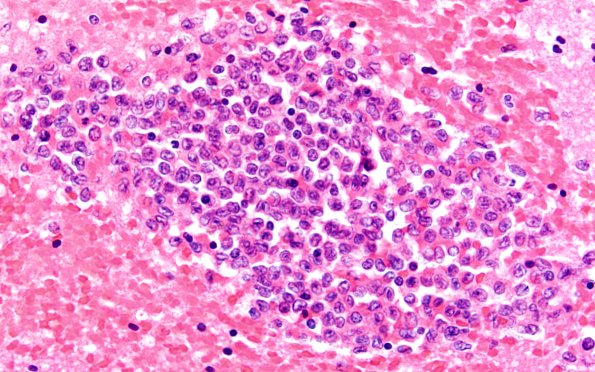
3B5 Leukemic Nodules (Case 3) 60X 1

Table of Contents
Washington University Experience | NEOPLASMS (HEMATOLYMPHOID) | Granulocytic Sarcoma | 3B5 Leukemic Nodules (Case 3) 60X 1
Higher magnification images of the nodule of image #3B1 demonstrating its myeloblastic center. Surrounding neural tissue showed acute white matter edema with ameboid glia and some karyorrhexis adjacent to the nodules (H&E)